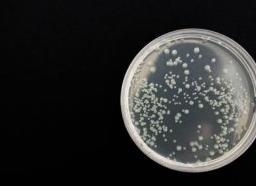
Молоко на стерильность как сдавать

Анализ грудного молока – как сдать молоко на анализ?
Анализ грудного молока на стерильность – это достаточно надежный и достоверный способ проверки грудного молока на наличие вредных бактерий, вызывающих кишечные расстройства и различные виды инфекционных заболеваний у малыша, а также воспалительные процессы у мамы.
Вопреки заблуждениям, грудное молоко не является абсолютно стерильным питанием для малыша – в нем могут жить микробы, бактерии и прочая микрофлора, которая может быть как безопасной для здоровья мамы и ребенка, так и представлять определенную угрозу. Чтобы исследовать эту микрофлору, необходимо сдать молоко на анализ.
Как бактерии могут проникнуть в грудное молоко? Обычно это происходит через микротрещинки в сосках. Сами по себе такие трещинки нисколько не опасны и не вызывают болезненных ощущений, но при малейшем ослаблении организма кормящей мамы болезнетворные стафилококки, стрептококки и грибки имеют все шансы проникнуть в молоко через эти уязвимые участки кожи. Возникновение микротрещин при постоянном прикладывании ребенка к груди неизбежно.
Показания для анализа
Бактериологическое исследование грудного молока обязательно проводится в следующих случаях:
- если кормящая мама перенесла гнойный мастит;
- если в первые два месяца жизни у малыша наблюдается резко нестабильный стул (темно-зеленого цвета, с примесями слизи и крови), колики, запоры и диареи в сочетании с низкой прибавкой массы тела;
- при наличии у ребенка гнойно-воспалительных заболеваний или сепсиса.
Таким образом, чаще всего сдать анализ бывает необходимо при повторяющихся маститах у кормящей мамы, и в более редких случаях – для нахождения причин заболеваний и нарушений процессов питания и пищеварения у малыша.
Подготовка к анализу
Чтобы сдать молоко на анализ, необходимо соблюдать аккуратность и предельную точность при его сборе – именно это является гарантией, что результаты анализа грудного молока будут достоверными. Важно понимать, что собрать грудное молоко нужно так, чтобы минимизировать возможность попадания в него бактерий с кожи.
Для сбора грудного молока необходимы две стерильные пробирки – отдельная для каждой груди. Также в качестве тары допускается использовать тщательно вымытые и простерилизованные в кипящей воде стеклянные баночки. Их нужно будет подписать, чтобы было понятно, в какой находится проба из левой груди, а в какой – из правой.
Непосредственно перед сбором молока для анализа руки и грудь нужно как следует вымыть с мылом. Кроме того, область ареол можно обработать спиртовым раствором или стерильной салфеткой. Затем нужно первую порцию молока из каждой груди сцедить в раковину, а вторую (около 10 мл) в заранее приготовленную тару.
Пробы грудного молока необходимо доставить в лабораторию для диагностики в течение двух–трех часов с момента сбора. Если сдать анализ грудного молока позже, можно получить неточные или совсем неправильные результаты. Обычно срок такого исследования составляет не меньше недели – это время необходимо для того, чтобы колонии бактерий успели вырасти и размножиться в питательных средах.
Процесс анализа
Для проведения исследования грудное молоко высеивают на специально подготовленную питательную среду, а после этого помещают в инкубатор. В течение нескольких дней в питательной среде образуются колонии микроорганизмов. Специалист исследует их и подсчитывает количество, тем самым определяя виды и число микробов, содержащихся в грудном молоке.
Одновременно с исследованием количества и качества бактерий в процессе анализа может быть получена информация об устойчивости выявленных микроорганизмов к воздействию различных лекарственных препаратов – антибиотиков и антисептиков. Это поможет найти оптимально подходящее средство для борьбы с инфекцией и назначить максимально эффективное лечение.
Результаты анализа
Очень важно понимать, что наличие в грудном молоке бактерий не обязательно указывает на развитие опасного инфекционного процесса и далеко не всегда требует прекращения кормлений и проведения какой-либо терапии. Микроорганизмы, обнаруженные в грудном молоке, могут попасть в него при сцеживании с рук или кожи груди. Таким образом, выявление бактерий может быть связано с обычными дефектами забора материала для анализа.
Кроме того, нельзя упускать из виду тот факт, что младенец при кормлениях в любом случае контактирует с микробами, находящимися на коже мамы, поэтому даже полная стерильность грудного молока не обеспечивает защиту ребенка. Так что какие-то нарушения в процессе пищеварения малыша можно связывать с результатами бактериологического анализа грудного молока только в очень редких случаях – при непосредственном обнаружении патологических микроорганизмов.
В некоторых случаях показаниями для посева грудного молока могут служить рецидивирующие гнойно-воспалительные заболевания кожи у ребенка или сепсис. В таких ситуациях по результатам анализа возможно назначение специальной терапии и даже прекращение грудного вскармливания. Также грудное кормление прекращают при обнаружении в молоке представителей патогенной микрофлоры, таких как сальмонеллы или холерные вибрионы.
У очень и очень многих кормящих мам, которым пришлось сдать анализ грудного молока, обнаруживаются условно-патогенные микроорганизмы. Самыми распространенными из них являются золотистый стафилококк и эпидермальный стафилококк. Но нельзя не отметить, что оба этих микроорганизма относятся к нормальным представителям микрофлоры, обитающими на коже человека. Поэтому при их выявлении не нужно бить тревогу.
В то же время и золотистый, и эпидермальный стафилококк способен вызвать мастит. Эти микроорганизмы относятся к условно-патогенной микрофлоре, а это означает, что они могут, как спокойно находиться в молочных протоках, не нанося никакого вреда маме и малышу, так и вызывать заболевания. Однако для этого им нужны определенные условия, такие как ослабленный иммунитет, неправильное питание.
Если сдать молоко на анализ без присутствия каких-либо признаков мастита, но при этом обнаружить в нем вредные бактерии, врач обычно назначает маме курс лечения, а малышу прописывает лакто — и бифидобактерии для профилактики дисбактериоза. Как правило, антибиотики используются в таких случаях крайне редко – обычно врач подбирает какие-нибудь растительные антисептики или бактериофаги, которые никак не повлияют на лактацию и не потребуют прекращения грудного вскармливания.
Для улучшения стерильности грудного молока можно и нужно использовать профилактические мероприятия. Во-первых, важно следить за питанием. Так, если кормящая мама употребляет много сладкого и мучных продуктов, это способствует размножению бактерий. Иногда матери стоит отказаться от такой пищи, и малыш сразу начинает чувствовать себя лучше. Во-вторых, нужно заботиться об эластичности нежной кожи ареол. Чтобы предотвратить образование микротрещин, через которые могут проникать бактерии, соски можно смазывать масляными растворами, содержащими витамины А и Е.
Грудное молоко — исследования на стерильность, расшифровка анализа
В каких случает требуется посев на стерильность. Как правильно подготовится в анализу. Как проводят в лабораториях посев и выявляют микробы? Расшифровка результатов. Что делать если норма бактерий превышает.
Когда требуется сдать посев грудного молока
Молоко женщина – это сложный биохимический элемент. Оно способно сформировать иммунитет малыша, укрепить его здоровье. Поэтому грудное вскармливание является самой лучшей пищей ребенка в первые его месяцы жизни.
Но случается так, что во время кормления грудью у женщины может развиться инфекция, вот тогда-то и есть опасность попадания вредоносных бактерий в молоко. Что может рассказать анализ на стерильность и как его проводят?
При исследовании молока в лаборатории, и определяется количество бактерий, и затем уже назначают лечение. Коварные микроорганизмы проникают в грудь женщины, через мелкие микротрещины, когда происходит кормление малыша.
Эти микротрещины образуются у всех кормящих мам, но вот проникновение вредоносных бактерий случается только у тех, чей организм ослаблен, в результате чего снижается иммунитет. Постоянные недосыпания, переутомления вызывают ослабление организма, и он становится уязвимым для инфекций.
Исследования грудного молока требуется в таких случаях:
- Когда в организме обнаружена любая послеродовая инфекция.
- При недоношенных родах.
- Если у младенца обнаружены гнойнички и сыпи.
- При жидком стуле и диарее у малыша.
- Донорстве молока.
- Лактозе, при застое молока женщины.
- Мастите, когда воспаляется молочная железа.
Посев необходим во всех перечисленных случаях. Так как именно этот анализ позволяет выявить, что стало причиной заболевания, определить возбудителя, и назначение лечения. Как правило, в таких случаях врачи требуют прекратить вскармливание.
Подготовка к посеву
Прежде чем приступить к сбору молока, требуется подготовить специальную стерильную емкость. На следующем этапе нужно обработать руки и грудь, предварительно их моют мылом, затем обрабатывают спиртом. Первые 5 миллилитром не сдают на анализ, поэтому их нужно слить.
Затем из каждой груди сцеживают по 10 мл и разливают в подготовленные емкости. Контейнера закрываются крышкой. Каждый контейнер маркируется, указывается возраст кормящей матери, фамилия, и из какой груди было взято грудное молоко.
Собранный материал желательно сдать в биолабораторию в течение двух – трех часов, но если такой возможности нет, то можно выдержать в холодильной камере не более 24 часов
Как в лабораториях проводят посев на выявление микробов?
Чтобы корректно определить стерильность грудного молоко, образцы специально высеивают на особую питательную среду. Затем её помещают в инкубаторий, и выдерживают некоторое время, до появления колоний бактерий. Затем, производится их подсчёт и определяют количество микроорганизмов в грудном молоке.
Проводя таким образом анализ на стерильность, доктора стараются выявить в молоке следующие инфекции:
- Стафилококк.
- Энтеробактерии.
- Кандидоз.
- Клебсиеллы.
Проводить исследования нужно в обязательном порядке, как только в организме мамочки начинаются воспалительные процессы. Быстрое и своевременное выявление микробов, позволяет начать действенную терапию. Тем самым оберегая организм малыша от бактерий, которые могут попасть с молоком.
Расшифровка анализа
Специалисты лабораторий проводя исследования с помощью специальной среды, и выявляют количество бактерий в грудном молоке. Известно, что молоко женщины содержит различные микроорганизмы. И допустимая их норма составляет:
- Правая грудь – 250 колоний на 1 миллилитр молока.
- Левая грудь – 250 колоний на 1 миллилитр молока.
Стафилококки и стрептококки в таком количестве не могут нанести вред малышу и кормящей женщине, поэтому это количество считается нормой.
Но если допустимая норма превышает и количество микроорганизмов постоянно растет, это уже вызывает тревогу. И стоит проводить немедленную терапию.
Микроорганизмы превышают нормы что делать?
Микроорганизмы в материнском молоке, могут представлять опасность для женщины и ребенка, когда налицо явные признаки мастита.
- Повышение температуры тела.
- Покраснение молочных желез.
- Невероятные боли в груди.
В этом случае врачи назначают антибиотики, и кормление грудью прекращается, так как это чревато для здоровья малыша. В остальных случает посев на стерильность, как правило, не делается. Микроорганизмы, присутствующие в грудном молоке не опасны для малыша. Они разрушается кислой средой во время кормления и в желудок ребенку не поступают.
Все проводимые исследования доказали, что в кал ребенку эти микроорганизмы не попадают. Бактерии живут вокруг нас повсеместно, и не стоит питаться защитить свою кроху от них, это будет бесполезно. Желательно вырабатывать стойкий иммунитет, чтобы организм сам мог бороться с атаками микробов.
И самым лучшим живым продуктом, который помогает выработать стойкий иммунитет и является грудное молоко. Поэтому не стоит прерывать кормление при обнаружении бактерий. Если у мамы нет мастита, то можно смело продолжать кормление, заботясь таким образом в первую очередь о ребенке.
(3 оценок, среднее: 3,67 из 5) Загрузка…
Анализ грудного молока на стерильность
Когда у кормящей мамы развивается инфекция, женщина переживает, не попадут ли бактерии в грудное молоко. Может ли в этом случае помочь анализ молока на стерильность и как его проводят?
Грудное молоко можно исследовать в лаборатории, определяя в нем количество бактерий. Также подобный анализ направлен на определение, к каким антимикробным средствам и бактериофагам чувствительны высеянные из молока патологические микроорганизмы.
Сдавать анализ молока на стерильность нужно, если:
- У кормящей женщины развился мастит.
- Нужно проконтролировать эффективность лечения антибиотиками.
- Имеется длительный понос у ребенка до 2 месяцев , который сочетается с недостаточной прибавкой в весе.
Кормящая мама особенно осторожно должна относиться к своей груди, поскольку очень часто мастит образуется именно после родов
Исследование очень важно для женщин, у которых развилось такое послеродовое осложнение, как мастит. Начальные стадии этого заболевания, называемые инфильтративной и серозной формами, способны быстро переходить в гнойную форму, что представляет опасность для кормящей мамы, а также для малютки.
Основными возбудителями данного осложнения являются стафилококки, энтеробактерии, стрептококки, синегнойные палочки и другие. Они нередко обладают устойчивостью к ряду антибактериальных средств, поэтому одновременно с выявлением бактерий, вызвавших мастит, важно узнать чувствительность микроорганизмов к лечебным средствам.
С помощью данного анализа выявляют микроорганизмы и грибки в женском молоке, а также определяют их количество. Анализ молока важно провести до назначения антибактериального лечения, а также рекомендуют повторить после того, как лечение окончено.
Посев молока на стерильность необходим для выявления опасных микроорганизмов в его составе
Молоко из разных грудных желез сдают на анализ отдельно. Собирать его лучше всего в стерильные емкости, которые выдают в лаборатории, выполняющей исследование молока на стерильность.
Прежде чем сцедить образец молока, грудь и руки следует помыть с использованием мыла, после чего протереть молочные железы в околососковой области ватными тампонами со спиртом (отдельным тампоном для каждой груди). Первые 5-10 мл молока, полученные из груди, для анализа не берут, поэтому их следует сцедить отдельно и вылить.
Далее 5-10 мл молока из каждой груди собирают в два стерильных контейнера, плотно закрывают их крышками и маркируют, указывая не только фамилию и дату рождения женщины, но и то, из какой молочной железы взят анализ.
До того, как отправить молоко в лабораторию, его можно держать дома в условиях холодильника до 24 часов. Однако лучше всего привезти емкости с образцами молока в лабораторию в течение двух часов после сцеживания.
Чтобы определить стерильность грудного молока, предоставленные образцы высеивают на особую питательную среду. Посеянную среду помещают в инкубатор и дожидаются появления колоний микроорганизмов. Эти колонии подсчитывают и определяют число бактерий в женском молоке.
Учет колоний проводят только для золотистого стафилококка, синегнойной палочки, кишечной палочки и других представителей патологической флоры. Обсемененность молока может быть немассивной, а также с массивным ростом – более 250 кое/мл. Интерпретацию результатов дает врач, учитывая клинические данные.
Сцеженное молоко анализируется на наличие патологических микроорганизмов.
Хотя данный анализ весьма популярен, но принципы доказательной медицины указывают на то, что большой ценности без учета клинической картины его результаты не имеют. Плохо и то, что он часто является поводом для назначения антибиотиков женщине и ребенку, которого можно было бы избежать. В норме грудное молоко не является стерильным, ведь оно выводится на поверхность кожи, заселенную даже у здоровых женщин разными видами микробов. И их попадание в грудное молоко совсем не удивительно. Так что лишь по расшифровке такого анализа на стерильность назначать кормящей маме антибиотики нельзя.
Результаты анализа могут подтвердить наличие болезни, если у кормящей мамы есть и другие симптомы инфекции – покраснение груди, интенсивные боли в молочной железе, повышенная температура тела. В других случаях определение бактерий в женском молоке не является важным критерием и проводиться не должно.
Переживать, что обнаруженные в материнском молоке микроорганизмы станут причиной дисбактериоза у младенца, не стоит. Изменение соотношения бактерий внутри кишечника малютки никак не связано с попаданием микробов с пищей, поскольку они разрушаются в желудке под действием соляной кислоты. Исследования подтвердили, что микроорганизмы из женского молока не попадают в кал малютки. К тому же, все бактерии, обнаруживающиеся в мамином молоке, есть также в большом количестве на других предметах, которые окружают младенца. И пытаться устранить бактерии в молоке, чтобы обезопасить кроху, бессмысленно.
Прерывать вскармливание ребенка грудью из-за обнаружения бактерий в молоке не нужно. Одновременно с молоком к малютке поступают и особые факторы против данных бактерий (в том числе антитела). Кипятить женское молоко, чтобы микробы были в нем уничтожены, тоже не рекомендуют, ведь молоко из женской груди после кипячения теряет значительное количество полезных свойств.
Так что, если у мамы отсутствуют признаки мастита, то обнаружение микробов в молоке не должно быть причиной назначения лечения. Детей также лечить не следует.
Анализ грудного молока кормящей матери на стерильность, антитела и бакпосев: как собрать, где сдавать и другие особенности
По результатам многочисленных исследований учёные определили, что для младенца первых двенадцати месяцев жизни грудное молоко является самым лучшим питанием. Состав ценной жидкости уникален и включает более пятисот полезных элементов. Если сравнить его с адаптированной детской смесью, то в её составе насчитывается не более пятидесяти компонентов. Поэтому многие молодые матери стремятся наладить и сохранить лактацию. Однако ослабленный организм женщины в период грудного вскармливания подвержен инфицированию. В некоторых случаях инфекция может попасть в материнское молоко. Чтобы получить точный ответ и назначить схему лечения, медики рекомендуют женщине сдать анализ питательной жидкости на стерильность, наличие патогенных бактерий, а также на антитела к инфекциям.
Когда необходимо сдавать грудное молоко на анализ
Материнское молоко не нуждается в предварительной термической обработке перед тем, как предложить его младенцу. Оно не только содержит в своём составе все необходимые витамины и питательные вещества для полноценного развития детского организма, но и является безопасным для крохи. Однако бывают ситуации, когда в питательную жидкость проникают патогенные микроорганизмы. В этом случае у ребёнка могут возникнуть проблемы со здоровьем.
Раньше медики считали, что материнское молоко полностью стерильно. Однако современная медицина доказала: в ценной жидкости могут присутствовать бактерии, микробы и грибки, которые не оказывают негативного влияния на организм крохи. Эти микроорганизмы относятся к условно-патогенной флоре: если её количество не превышает допустимый уровень, негативные симптомы не возникают. Однако ослабленный иммунитет часто не может справиться с ростом микроорганизмов, тогда их число увеличивается, и это отрицательно сказывается на состоянии здоровья. Например, грибки рода Candida постоянно живут и на слизистых здорового человека, но как только защитные силы ослабевают, грибки размножаются и врач диагностирует кандидоз (молочницу).
Именно во время первого прикладывания к груди сразу после рождения в стерильный желудок ребёнка с капельками молозива попадают такие микроорганизмы, создавая нормальную кишечную микрофлору.
Многим кормящим мамам рекомендуют сдать грудное молоко на анализ
В период лактации не рекомендуется заниматься самолечением, т. к. неправильно поставленный диагноз и запущенное заболевание часто приводят к ухудшению ситуации. А также стоит помнить, что во время кормления грудью большинство медикаментозных препаратов запрещены к применению, чтобы не навредить младенцу. Поэтому при первых неприятных признаках болезни необходимо обратиться за помощью к доктору.
Если кормящую маму беспокоят неприятные ощущения в молочных железах или у ребёнка проявилась какая-либо отрицательная реакция после кормления, необходимо обязательно проконсультироваться с врачом. Прежде чем определить верный диагноз и разработать схему лечения, доктор может назначить ряд анализов, по результатам которых специалист будет знать, есть ли воспалительный процесс в организме кормящей матери, а также какая инфекция стала причиной заболевания.
Медики рекомендуют сдать анализ грудного молока на бакпосев, если у матери или младенца проявляются следующие неприятные симптомы:
- кормящей матери поставили диагноз гнойный мастит — в этом случае к воспалению тканей молочной железы уже присоединилась инфекция и без антибиотикотерапии не обойтись;
- гнойные выделения из сосков у молодой мамы;
- у младенца появились сильные высыпания, гнойнички на кожном покрове и слизистых оболочках;
- частые срыгивания и рвота у крохи;
- постоянная диарея, наличие слизи, крови в каловых массах у ребёнка;
- дисбактериоз кишечника у малыша. Заболевание проявляется расстройством пищеварения, чрезмерным газообразованием, коликами.
Для чего сдают анализ материнского молока на бакпосев
Анализ грудного молока на бактериальный посев необходимо сдавать в случае, когда необходимо определить, какая инфекция проникла в питательную жидкость. Современные лаборатории в заключении не только обозначают наличие патогенной флоры, но и дополняют результаты списком действующих веществ медикаментозных препаратов, которые эффективно справятся с этими микробами.
Подействует ли лечение, во многом зависит от индивидуальной особенности организма кормящей матери. Например, у двух женщин с одинаковым диагнозом одно и то же лекарство может по-разному воздействовать на возбудителя заболевания: одна мама полностью вылечится, а у другой не будет положительного эффекта и инфекция останется в грудном молоке.
Поэтому анализ на бакпосев подразумевает и тест на чувствительность патогенной флоры к антибиотикам и бактериофагам (это полезные вирусы, которые проникают только в клетки бактерий и уничтожают их, при этом не поражая здоровые клетки и полезные микроорганизмы человека). По результатам исследования врач подберёт препарат, который точно поможет справиться с инфекцией.
В грудное молоко чаще всего попадают грибки рода Candida и золотистый стафилококк. Именно последний патоген провоцирует серьёзные проблемы со здоровьем у младенца.
Анализ грудного молока на бакпосев помогает выявить наличие бактерий и патогенов в жидкости
Что такое анализ на антитела и в каких случаях кормящей матери необходимо пройти это исследование
Анализ грудного молока на антитела рекомендуется сдавать женщинам, у которых обнаружен резус-конфликт с ребёнком. Это значит, что у мамы и младенца не совпадает резус-фактор крови: у женщины он отрицательный, а у малыша — положительный. Ещё во время беременности в организме матери могут начать вырабатываться антитела, которые могут проникать через плаценту и отрицательно воздействовать на развитие будущего младенца. Медики предупреждают, что попадание антител с грудным молоком в организм новорождённого приводит к развитию некоторых заболеваний и негативно отражается на здоровье крохи. Поэтому врачи должны знать, есть ли в питательной жидкости такие антитела, чтобы разрешать (или запретить) молодой матери кормить младенца грудью.
Обычно женщинам с резус-конфликтом позволяют прикладывать малыша к груди по истечении десяти-двенадцати дней после родов. За это время опасные антитела обычно исчезают из организма женщины. Однако каждая мама индивидуальна, поэтому некоторым запрещается кормить ребёнка грудным молоком около месяца.
Если в заключении лаборатории написано, что антител в материнском молоке не обнаружено, это значит, что женщина может кормить младенца грудью не беспокоясь. В некоторых случаях медики разрешают дать младенцу молозиво сразу после родов и следят за реакцией его организма. Но чаще врачи принимают решение подождать и предлагают молодой матери сдать анализ на антитела, который точно покажет, не будет ли вреда здоровью крохи от материнского молока.
Подготовка к анализу и правила сбора молока
Перед тем как сдавать анализ, необходимо знать, как подготовить молочные железы к сбору питательной жидкости и как правильно это сделать. Молодая мама должна понимать, что ошибки могут привести к недостоверному результату, поэтому необходимо тщательно подойти к процедуре сбора грудного молока.
Для уточнения информации необходимо позвонить или лично прийти в лабораторию. Медицинский персонал обязательно проинформируют кормящую мать о правилах и основных нюансах подготовки к такому важному анализу.
Для того чтобы результаты были верными, необходимо следовать инструкции:
- Прежде всего нужно подготовить ёмкость для сбора молока. Лучше всего купить специальные стерильные баночки. Они продаются в любой аптеке. В этом случае женщина может быть уверена, что жидкость будет собрана в идеально чистый контейнер.
Некоторые кормящие матери предпочитают взять любую маленькую баночку, например, из-под детского питания. Это не запрещается. Однако перед сбором грудного молока её необходимо простерилизовать.
- Если доктор назначил сдать анализ из двух молочных желёз, то понадобятся две отдельные баночки. На каждой из них необходимо сделать запись, из какой груди будет сцежена питательная жидкость.
- Теперь можно приступать непосредственно к сбору молока. Прежде всего нужно тщательно вымыть руки и молочные железы с мылом. Затем взять чистое полотенце и вытереть руки. Нежную кожу груди лучше протереть салфеткой, чтобы не травмировать кожный покров.
- Следующий шаг — протереть область соска и ореолы спиртом 70%. Это необходимо для того, чтобы бактерии, которые присутствуют на коже, не попали в материнское молоко при сцеживании.
- Первые десять миллилитров жидкости из каждой груди необходимо просто сцедить. Эта порция молока не подходит для анализа.
- Затем нужно собрать ещё по 10 мл молока в стерильные контейнеры с каждой молочной железы.
- После сцеживания достаточного количества жидкости баночки нужно плотно закрыть крышками и не забыть подписать.
Медики обращают внимание, что контейнеры с материнским молоком для анализа необходимо доставить в лабораторию не позднее чем через два часа после сцеживания жидкости. Если молодая мама не успеет этого сделать, анализ будет недостоверным. Также лаборанты объясняют, что бактериологический посев требует около шести-семи дней для получения результата. Поэтому придётся запастись терпением и ждать.
В лаборатории определят, присутствует ли в грудном молоке патогенная флора
Как происходит инфицирование молока
Казалось бы, как инфекция может попасть в грудное молоко. Однако это происходит и довольно часто. Дело в том, что сначала патогенные микроорганизмы попадают в молочные протоки, а затем — в питательную жидкость. Путь инфицирования начинается с образование мелких ранок на нежной коже сосков. С проблемами появления трещин сталкиваются многие кормящие матери, особенно в первый один-два месяца после рождения малыша:
- кроха неправильно захватывает грудь: в ротовую полость попадает только сосок, без ареолы;
- мама слишком резко вынимает сосок изо рта младенца: происходит повреждение нежной кожи;
- длительное время кормления: ребёнок уже наелся, но продолжает сосать грудь;
- также ошибки кормящей матери часто становятся причиной образования ранок: ношение тесного нижнего белья, неиспользование увлажняющих или защитных кремов для области сосков и другие.
Если не ухаживать за сосками, не защищать нежный кожный покров, то травмирование неизбежно. Через эти ранки инфекция легко проникает в питательную жидкость. Организм матери реагирует на это развитием воспалительного процесса — мастита. В случае не вовремя начатого лечения состояние ухудшается и у женщины начинается гнойный мастит. В некоторых случаях медики не только назначают антибиотикотерапию, но и прибегают к хирургическому вмешательству, чтобы очистить проток от гноя. Организм малыша, которые ещё не может в полной мере противостоять инфекции, также страдает. Патогенная флора провоцирует проблемы с кожным покровом и негативно влияет на пищеварительную систему. В некоторых случаях поражается и дыхательная система ребёнка: у малыша диагностируют ангину, или тонзиллит (воспалительное заболевание миндалин), отит (воспаление ушных раковин).
Медики рекомендуют заранее готовить грудь к кормлению, а также использовать специальные средства защиты для сосков, чтобы предотвратить образование трещин.
Профилактика попадания инфекции в грудное молоко
Инфекция попадает в материнское молоко через ранки на сосках. Однако большую роль играет и состояние защитных сил женщины. Если молодая мама постоянно устаёт, мало спит и не получает положительных эмоций, иммунитет не может в полной мере противостоять патогенным микроорганизмам. Поэтому необходимо принимать комплексные меры профилактики попадания бактерий в грудное молоко:
- следить, чтобы ребёнок правильно брал грудь. Младенец должен захватывать не только сосок, но и ореолу. Во время сосания подбородок тесно соприкасается с молочной железой;
- соблюдать правила личной гигиены. Если раньше рекомендовалось мыть грудь с мылом перед каждым кормлением крохи, то сейчас современные медики не советуют так делать. Достаточно принимать душ два раза в день: утром ополоснуться тёплой водой, а вечером искупаться с гипоаллергенным гелем для душа. Этого будет достаточно, ведь частые водные процедуры смывают защитный слой в нежной кожи, поэтому соски травмируются намного чаще;
- не стоит тереть молочные железы полотенцем после купания. Используйте бумажные полотенца или салфетки. Для удаления влаги необходимо применять промакивающие движения;
- отдавать предпочтение только качественному нижнему белью. Сегодня в продаже есть специальные бюстгальтеры для кормящих мам, которые изготовлены из натуральных тканей и позволяют коже дышать;
- если есть необходимость, нужно обязательно использовать прокладки для груди, чтобы намокшая одежда не натирала кожный покров в области сосков;
- не забывать о ежедневных воздушных ваннах для молочных желёз. Достаточно делать это два раза в день сразу после купания;
- следить за питанием: меню кормящей матери должно быть сбалансированным и разнообразным. Также не будет лишней консультация с доктором, который подберёт специальный мультивитаминный комплекс для кормящих матерей;
- не использовать средства, в составе которых присутствует спирт. Эти препараты могут пересушить кожу сосков, что станет причиной возникновения трещин;
- пользоваться специальными защитными кремами для сосков, чтобы предотвратить травмирование нежной кожи;
- если трещины уже появились, необходимо посоветоваться с врачом. Специалист назначит специальные препараты, которые помогут скорейшему заживлению ран и предотвратят организм от инфицирования;
- при обнаружении уплотнений, комков в молочных железах, гнойных выделений из сосков, обязательна консультация со специалистом.
Правильный уход за молочными железами во время лактации обеспечит защиту нежной кожи от появления трещин: таким образом инфекция не сможет проникнуть в грудное молоко
Где можно сдать грудное молоко на анализ
Услуги по исследованию грудного молока предлагают частные медицинские центры или лаборатории. Женщина может самостоятельно принять решение о необходимости сдать этот анализ или прийти с направлением от врача, который посчитал необходимым провести обследование.
Следует знать, что по полису ОМС нет возможности сдать данный анализ бесплатно. Во многих поликлиниках в лабораториях нет специального оборудования для определения наличия или отсутствия микроорганизмов в материнском молоке.
Чтобы получить достоверный результат, необходимо оборудование, а также специально обученный персонал. Современные частные лаборатории имеют необходимую техническую базу, поэтому, если кормящей матери нужно сдать этот анализ, можно обратиться в одно из таких учреждений. Стоимость услуги зависит от ценовой политики лаборатории: в некоторых медицинских заведениях она будет на порядок выше, в других — ниже.
Немного о результатах и возможности продолжать ГВ
В бланке с результатами анализов может быть несколько вариантов:
- В грудном молоке, предоставленном для проведения исследования, не выявлен рост микрофлоры. Это говорит о чистоте питательной жидкости. Однако стоит понимать, что такой результат — скорее редкость, чем правило.
- В лаборатории обнаружили, что есть небольшой рост энтерококка или эпидермального стафилококка. Не стоит паниковать раньше времени и сразу прекращать прикладывать малыша к груди. Такой результат считается вариантом нормы, т. к. эти микроорганизмы могут присутствовать в грудном молоке, однако не представляют опасности для здоровья матери или малыша.
- Обнаружен золотистый стафилококк, дрожжеподобные грибки или другие патогены. В этом случае женщине необходимо пройти лечение незамедлительно.
Молодая мать должны быть готова к тому, что в некоторых ситуациях доктор может запретить кормление грудью на время прохождения лечения. Однако вопрос о невозможности прикладывания младенца к соску решает только специалист. Не стоит самостоятельно лишать кроху питательной жидкости из-за страха или боязни навредить ребёнку. Знаменитый педиатр Евгений Олегович Комаровский уверен, что при обнаружении стафилококка в грудном молоке прекращать лактацию необязательно: если у кормящей матери нет признаков развития мастита, а у крохи всё в порядке с состоянием здоровья, то разрешается продолжать ГВ. В этом случае женщине назначают курс антибиотиков, совместимых с грудным вскармливанием, а малышу рекомендуется пропить препараты с лакто- и бифидобактериями, чтобы нормализовать микрофлору кишечника.
Видео: доктор Комаровский о стафилококке в грудном молоке
Грудное молоко необходимо для полноценного развития младенца. Огромное количество полезных элементов, а также иммуноглобулины способствуют повышению иммунитета и защите организма маленького человека от инфекций и патогенной флоры. Однако при появлении неприятных симптомов у матери или малыша специалисты рекомендуют сдать ценную жидкость на анализ, чтобы узнать, есть ли вредоносные микробы в молоке. Очень часто золотистый стафилококк или грибки являются причинами появления проблем со здоровье у ребёнка. После получения результатов врач назначит эффективное лечение, которое поможет справиться с инфекцией.
- Автор: Наталия Волобуева
- Распечатать